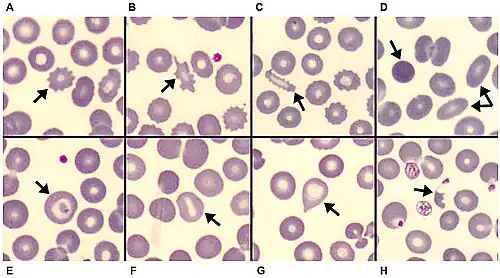

Elliptocyt
Elliptocyten of ovalocyten zijn abnormaal gevormde rode bloedcellen die ovaal of langwerpig lijken, van licht eivormig tot staaf- of potloodvormig. De lange as van de elliptocyt is minstens twee keer zo lang is als de korte as, anders is het een ovalocyt.[1]. Ze hebben een normale centrale lichte vlek, waarbij de hemoglobine geconcentreerd lijkt aan de uiteinden van de langwerpige cellen wanneer bekeken door een lichtmicroscoop. De uiteinden van de cellen zijn stomp en niet scherp zoals bij sikkelcellen.[2]
Elliptocyten worden vaak geassocieerd met de erfelijke aandoening elliptocytose. Ze kunnen echter ook worden gezien bij ijzergebreksanemie, sepsis, malaria, myelofibrose, thalassemie en andere pathologische aandoeningen die de omzet en/of productie van rode bloedcellen verminderen.[3] In het geval van ijzergebreksanemie zouden microcytose en chlorose ook verwacht kunnen worden.[4]
![]() |
![]() |
![]() |
Voetnoten
- ↑ Marc Zandecki, Morphologie érythrocytaire (partie 2) : anomalies de forme des globules rouges, Elliptocytes, ovalocytes, Laboratoire d'Hématologie Cellulaire du CHU d'Angers
- ↑ Ovalocytes/Elliptocytes - LabCE.com, Laboratory Continuing Education. www.labce.com. Geraadpleegd op 21 May 2018.
- ↑ Clinical hematology and oncology : presentation, diagnosis, and treatment, Bruce Furie. Churchill Livingstone, Philadelphia, Pa. (2003), 276–278. ISBN 0-443-06556-X.
- ↑ Robbins & Cotran pathologic basis of disease, Vinay Kumar, Abul K. Abbas, Jon C. Aster, James A. Perkins, 10th, Philadelphia, PA (2021). ISBN 978-0-323-53113-9.
Bronvermelding
- Dit artikel of een eerdere versie ervan is een (gedeeltelijke) vertaling van het artikel Elliptocyte op de Engelstalige Wikipedia, dat onder de licentie Creative Commons Naamsvermelding/Gelijk delen valt. Zie de bewerkingsgeschiedenis aldaar.